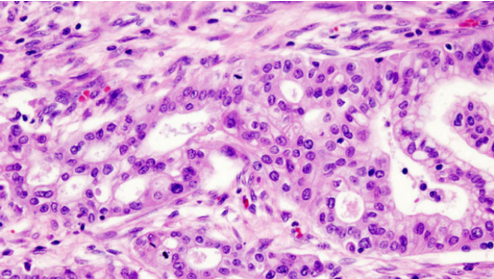

胰腺(图片来自:WIKIMEDIA, USER:KGH)
“癌症之王”,早期确诊率不高
胰腺癌被医学界誉为“癌症之王”,仅在美国每年就有超过 53,000 人被诊断患有胰腺癌。
它是一种恶性程度很高,诊断和治疗都很困难的消化道恶性肿瘤,约 90% 为起源于腺管上皮的导管腺癌。一方面,胰腺癌的 5 年生存率 <1%,是预后最差的恶性肿瘤之一;另一方面,胰腺癌早期的确诊率不高,手术死亡率较高,而治愈率很低。
意大利男高音歌唱家帕瓦罗蒂、“肥肥”沈殿霞以及苹果之父乔布斯都因胰腺癌去世。
在过去,大多数胰腺癌患者直到晚期才被诊断出来,超过了手术切除肿瘤的时间。一般来说,发现罹患胰腺癌时,肿瘤往往已经大到无法治疗。患者在确诊罹患胰腺癌后,5 个病患中有 4 人会在 1 年内病逝。
联合生物标志物,让胰腺癌早发现早治疗

胰腺(图片来自:http://www.medindia.net)
近日,来自宾夕法尼亚大学 Perelman 医学研究所的科学家证实:通过最新发现的生物标志物平台(biomarker panel),胰腺癌可以在早期被发现且治疗可控。这项研究被发表在近日的 Science 子刊 Science Translational Medicine 上。
研究团队使用廉价的市售蛋白质测定法筛选合适的候选生物标志物——血浆凝血酶敏感蛋白 -2(THBS2),以区分 746 例癌症和对照血浆样品。结果发现 THBS2 的血液水平与已知的晚期生物标志物 CA19- 9 的水平相结合,在检测患者胰腺癌的可能性方面是可靠的,可以有效检测患者在不同阶段血液样本中的胰腺癌细胞水平。
这项研究由宾大再生医学研究所主任 Ken Zaret 教授和来自梅奥医院的 Gloria Petersen 领衔,他们表示,联合血液标志物如血浆凝血酶敏感蛋白 -2(THBS2)、CA19- 9 等,胰腺癌中的肿瘤细胞可以被早期发现。
研究共同作者、宾夕法尼亚大学 Abramson 癌症中心负责人 Robert Vonderheide 教授表示,胰腺癌患者确诊时往往已经太迟,错失最有效的治疗良机,这是他们长久以来的忧虑。替胰腺癌做生物标记测试,可望大大扭转这些病患的未来。
科普小知识:早期容易与胰腺癌混淆的几种病症
1)胃病:上腹部饱胀不适及隐痛是胰腺癌最常见的首发症状,30% 到 40% 患者会出现该表现,若病变累及腹腔神经丛则腰背也会随之疼痛,易被当作胃痛或腰肌劳损而自行服药治疗。需要区分的是,胃病尽管可出现上腹痛,但吃胃药就基本能控制症状。而胰腺癌的腹痛不但服药无效,且呈持续性、基本无明显缓解时间。
2)黄疸:胰腺癌的黄疸特点是不断加重且无痛感。如患者首先眼球巩膜发黄,然后小便颜色变深,可逐渐由橘黄色变至酱油色,大便颜色也会逐渐变淡,直至呈白陶土色,同时全身皮肤变黄。当出现黄疸时,尤其还伴有上腹隐痛、闷胀等类似消化不良症状或体重减轻等表现,最好先到正规医院进行胰腺 B 超、CT 等相关检查,以尽早排除或确诊胰腺癌,争取治疗时间。
3) 糖尿病:从生理功能角度来看,胰腺兼具外分泌和内分泌两大主要功能。外分泌功能主要指分泌含有各种消化酶的胰液,内分泌功能则是通过分泌多种激素调节人体各项机能,这其中最广为人知的便是分泌胰岛素调节人体血糖变化。如果胰腺功能出现障碍,会导致人体血糖增高。反之,糖尿病患者由于局部免疫功能异常,也会导致胰腺出现进一步恶变的可能。因此,糖尿病患者也是胰腺癌的高危人群。
备注:本文科普内容参考自“杏仁医生”。
参考资料:
Detection of early pancreatic ductal adenocarcinoma with thrombospondin-2 and CA19-9 blood markers
Study: Blood Test Detects Pancreatic Cancer
Combined Biomarkers Help Detect Pancreatic Cancer Early
扫描上面二维码在移动端打开阅读